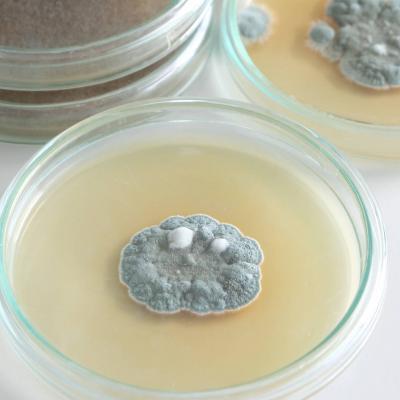

La scoperta della penicillina: l’errore che ha cambiato la storia della medicina
Nel cuore del XX secolo, in un laboratorio londinese scarsamente illuminato, si stava per compiere un errore che avrebbe segnato l’inizio di una nuova era per la medicina. Era il 1928 quando Alexander Fleming, un microbiologo poco più che quarantenne, tornò dalla sua vacanza con un’insolita scoperta: un piatto di Petri contaminato da muffa, capace di uccidere i batteri. Questo episodio, apparentemente fortuito, si trasformò in una rivoluzione terapeutica, dando vita alla penicillina e inaugurando l’era degli antibiotici. Attraverso le pagine di questo articolo, esploreremo come un semplice errore di laboratorio abbia non solo risollevato milioni di vite, ma abbia anche ridisegnato il panorama della medicina moderna, aprendo la strada a trattamenti e scoperte impensabili fino ad allora.
La genesi fortuita di una rivoluzione: come un errore ha aperto le porte alla penicillina
Il racconto della scoperta della penicillina è intriso di casualità e destini incrociati. Georges Friedrich, un umile batteriologo, non avrebbe mai immaginato che un suo semplice errore potesse cambiare il corso della storia della medicina. Era l’89 e il suo laboratorio a Londra era un brulichio di provette, colture e osservazioni. Come accade nella vita delle persone creative e geniali, il caos era una parte integrante delle sue giornate di lavoro.
Una mattina, dopo una breve assenza dal laboratorio, Friedrich tornò e si accorse che una delle sue colture di Staphylococcus aureus era stata contaminata da una muffa. Inizialmente, provò a scartare il campione, ma poi decise di esaminare più da vicino la contaminazione. Con sua grande sorpresa, notò che attorno alla muffa vi era una zona completamente priva di batteri. Era un segno inaspettato e sorprendente. Questo incidente, che per molti sarebbe stato solo un disguido, divenne il primo passo verso una rivoluzione che avrebbe salvato milioni di vite.
La muffa in questione era della specie Penicillium notatum. Friedrich, spinto dalla curiosità, iniziò a sperimentare con il microrganismo. Prese a estrarre composti dalla muffa, realizzando che vi era qualcosa di straordinario nel loro potere antibatterico. Per lui, era un mistero avvincente. La scoperta di Friedrich non si limitava a una semplice reazione chimica; era un’opportunità per comprendere come un singolo errore potesse portare a un cambiamento radicale nel trattamento delle malattie infettive.
In seguito agli esperimenti, Friedrich comunicò i suoi risultati ai colleghi, ma inizialmente non ricevette il riconoscimento sperato. La scienza, come spesso accade, era piena di scetticismo. Solo grazie alla tenacia di alcuni medici, fra cui Alexander Fleming, si riuscì a far luce sul potere curativo della penicillina. La collaborazione tra scienziati rivelò il potenziale di un’invenzione che stava ancora aspettando di essere colta. Così, il mondo scientifico cominciò a prestare attenzione a questo antibiotico rivoluzionario.
I benefici della penicillina divennero evidenti molto rapidamente. Durante la Seconda guerra mondiale, questo nuovo farmaco si rivelò vitale nel curare ferite e infezioni batteriche, riducendo significativamente i tassi di mortalità tra i soldati. Ciò non solo cambiò il modo in cui si affrontavano le infezioni ma trasformò anche l’approccio alla salute pubblica e alla medicina in generale. Per la prima volta, boschi di speranze e miglioramenti medici si aprirono all’orizzonte.
Ma oltre al suo utilizzo immediato, la penicillina aprì le porte a un’intera nuova era di studi. In seguito alla sua scoperta, molti altri antibiotici vennero sviluppati, ciascuno con il proprio metodo d’azione. Gli scienziati iniziarono a esplorare l’intero regno dei funghi e dei batteri, cercando nuove potenzialità terapeutiche. La penicillina divenne la pietra miliare di un movimento che permise l’avanzamento della farmacologia e della microbiologia.
Nonostante i suoi straordinari vantaggi, la scoperta della penicillina fu anche il seme per nuove sfide. Con l’aumento della prescrizione di antibiotici, si iniziò a notare una crescente resistenza batterica. Questo fenomeno sollevò interrogativi cruciali riguardo alla sostenibilità dell’uso di antibiotici. La storia ci insegna che ogni conquista, per quanto grande, richiede una riflessione e una responsabilità etica che non dovremmo mai trascurare.
Friedrich, il cui errore casuale portò a questa scoperta epocale, rimane una figura emblematiche della capacità umana di apprendere e adattarsi. Attraverso il suo lavoro, dimostrò che le potenzialità di una scoperta scientifica possono risiedere là dove meno ce lo aspettiamo. Ogni ricercatore dovrebbe trarre ispirazione dalla sua storia, ricordando che anche un piccolo errore può condurre a un enorme progresso. La penicillina, dunque, non è solo un farmaco: è un simbolo di speranza, di resilienza e della continua ricerca della conoscenza.
La genesi fortuita della penicillina non è da considerarsi un episodio isolato ma piuttosto un capitolo di una continua narrazione scientifica. Esplorando il potere di un errore, possiamo scoprire che ogni errore, se analizzato con apertura mentale e curiosità, ha il potenziale di cambiare il nostro mondo.